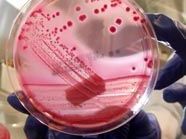

Die 32-jährige, deutsche EHEC-Patientin im AKH ist Herz-Kreislauf-stabil und wurde bereits mobilisiert. "Sie ist bereits einige Schritte im Zimmer gegangen", sagte eine Sprecherin des Wiener Krankenanstaltenverbundes (KAV).
EHEC-Fälle in Europa
Gurken sind nicht Auslöser
Neuer EHEC-Stamm verantwortlich
Kein EHEC in Gemüse aus Ö
Touristin im Wien erkrankt
EHEC: Restaurant im Visier
Lebensgefahr im Wiener AKH
Schon 22 Tote in Deutschland
Auf die Typisierung des Erregers werde man allerdings noch länger als angenommen warten müssen. Zunächst war man davon ausgegangen, dass es Dienstagnachmittag soweit sein wird. Jetzt rechnet man mit einem Ergebnis bis Ende dieser Woche. Damit weiß man, ob es sich um eine Infektion mit den aggressiven EHEC-Bakterien und der nachfolgenden Komplikation des hämolytisch-urämischen Syndroms (HUS) handelt.
Wie bei den Patienten in Deutschland wurde auch bei der 32-Jährigen mit einer Antikörpertherapie begonnen. Wie sie darauf anspricht, werde sich in den nächsten Tagen zeigen, so die KAV-Sprecherin. (APA/Redaktion)